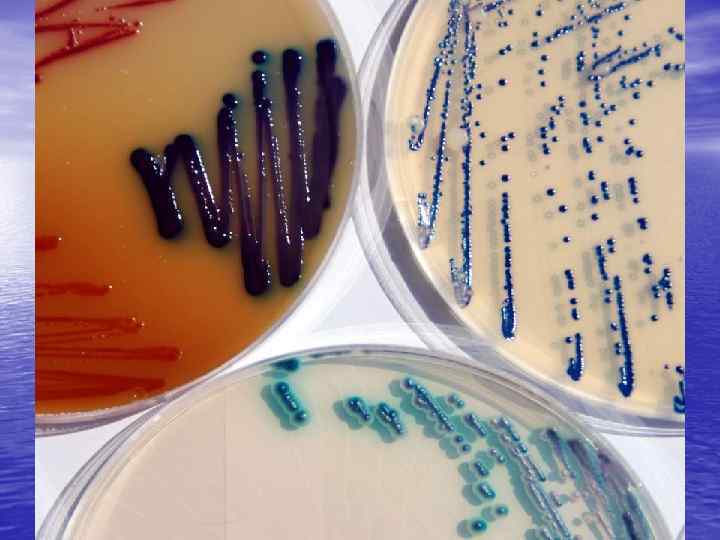

Рост бактерий в периодической и непрерывной культуре.ppt
- Количество слайдов: 14

Рост бактерий в периодической и непрерывной культуре Выполнила: ученица второго курса Вавилина Анна

• Культивирование микроорганизмов можно поводить поверхностным или глубинным, периодическим или непрерывным методами, в аэробных или анаэробных условиях. Большое значение при выборе способа культивирования имеет отношение выбранного для культивирования микроорганизма к молекулярному кислороду и конечная цель культивирования: накопление биомассы или получение определенного метаболита (спирта, кислорода, фермента и т. д. ).


• При периодическом методе культивирования весь объем питательной среды засевают чистой культурой, и выращивание ведут в оптимальных условиях определенный период времени до накопления нужного количества целевого продукта. Поскольку культивирование ведется на невозобновляемой питательной среде (в стационарных условиях), клетки все время находятся в меняющихся условиях. Сначала они имеют в избытке все питательные вещества, затем постепенно наступает недостаток питания и отравление вредными продуктами обмена. В связи с этим культура в своем развитии проходит четыре фазы роста и размножения, в течение которых изменяются размеры клеток, скорость размножения, морфологические и физиологические свойства


• Первая стадия - лаг-фаза, или фаза задержки • роста, следует непосредственно за внесением посевного материала в питательную среду. В этой фазе микроорганизмы не размножаются, а приспосабливаются к среде, происходит повышение содержания нуклеиновых кислот, увеличение размера. Эта стадия является подготовкой к дальнейшему интенсивному синтезу белка клеткой, т. е. ее росту и размножению. Вторая стадия - фаза логарифмического роста(экспоненциальная) характеризуется высокой скоростью размножения клеток, так как в среде много питательных веществ и мало вредных продуктов обмена. Время, необходимое для удвоения числа клеток, называется продолжительностью генерации. В благоприятных условиях клетки бактерий делятся каждые 20 -30 мин, их число увеличивается в геометрической прогрессии (1, 2, 4, 8, 16 и т. д. ).


• Третья стадия - стационарная (фаза зрелости), когда размножение микроорганизмов замедляется, и скорости размножения и отмирания уравновешиваются, в результате чего число клеток остается постоянным. • Четвертая стадия - фаза отмирания, когда начинается гибель клеток и их количество снижается за счет отмирания и автолиза (самопереваривания).

Закономерность роста чистой культуры микроорганизма • а - лаг-фаза; б - логарифмическая фаза; в - стационарная фаза; г- фаза отмирания.

• Периодическое культивирование осуществляется во многих производствах, основанных на жизнедеятельности микроорганизмов. Недостатком периодического культивирования являются нерациональные затраты времени на прохождение всех четырех стадий развития культуры, причем период самой активной жизнедеятельности - фаза логарифмического роста - занимает небольшую часть производственного цикла.

• В течение последних тридцати лет все большее значение приобретает более прогрессивный метод непрерывного культивирования микроорганизмов, который состоит в том, что культура находится в специальном аппарате, куда постоянно притекает свежая питательная среда и с такой же скоростью отводиться культуральная жидкость. Посевной материал выращивается до стадии логарифмического роста и вносится в питательную среду. Длительность периода логарифмического роста зависит от количества питательных веществ в среде, а также от количества вредных продуктов обмена, выделяемых клеткой.

• В последние годы активно разрабатывается и • применяется метод непрерывного культивирования клеток микроорганизмов в иммобилизованном(прикрепленном) состоянии - на пленках, гранулах, волокнах специально подобранных синтетических полимерных материалов. Иммобилизованные клетки микроорганизмов функционируют многократно и в течение длительного времени сохраняют высокую биохимическую активность. Непрерывное культивирование очень перспективно и широко используется в пищевой и микробиологической промышленности и создает возможность автоматического поддержания заданных оптимальных условий, благодаря чему обеспечивается стандартность готового продукта при наименьших затратах.

Рост бактерий в периодической и непрерывной культуре.ppt